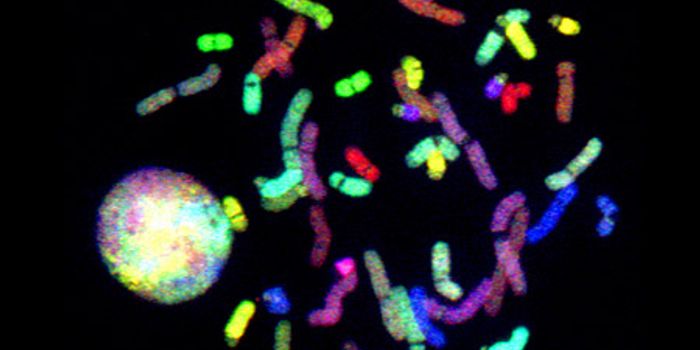
Discoveries in 3-D Genome Make-Up and Genetic Changes: Clarification of differences amidst chromosome pairs and how gene expression is effected by chromosome folding

Epigenome
The epigenome is a term used to describe all the molecular modifications on DNA within a single cell. Epigenetic markers vary between cell types. The epigenome does not alter the DNA sequence but influences the way cells use genetic information contained in the DNA.
-
OCT 24, 2017Health & MedicineWhen a woman is pregnant, it's often said that she is eating for two. While that may be true, what matters more than ...Written By: Brenda Kelley KimJAN 21, 2017CancerActing like cunning thieves in the night, pancreatic cancer can hack into their microenvironment to selfishly steal the ...JAN 17, 2017Genetics & Genomicsepigenetics initiates pancreatic cancer metastasisWritten By: Jennifer EllisDEC 16, 2016Cell & Molecular BiologyReporting in Cell, scientists were able to extend the lifespan of mice that carry a genetic mutation that causes prematu ...Written By: Carmen LeitchDEC 13, 2016Cell & Molecular BiologyBrains are complex; studying brain function often involve simple organisms, like honeybees, which provided a finding tha ...Written By: Carmen LeitchNOV 23, 2016MicrobiologyThere is a rich community of microbes residing in the gastrointestinal tracts of animals including humans, the microbiom ...Written By: Carmen LeitchNOV 20, 2016Cell & Molecular BiologyA study published in Cell demonstrated how the brains of patients with different kinds of autism spectrum disorder (ASD) ...Written By: Carmen LeitchAUG 22, 2016Cell & Molecular BiologyEgg cells, or ovules in animals, remain dormant for many years after the start of reproductive age, and that is one reas ...Written By: Carmen LeitchJUL 02, 2016VideosOur genes make us. They decide our height, the sound of our voice, and even how athletic we are. Yet, how is it that ide ...Written By: Julianne ChiaetJAN 11, 2016Genetics & GenomicsFrom the Sanger Institute/ EMBL-EBI Single Cell Genomics Centre, scientists say it is now possible to assay both DNA met ...Written By: Kara MarkerDEC 31, 2015Health & MedicineOur genes make us. They decide our height, the sound of our voice, and even how athletic we are. We’ll alwa ...Written By: Julianne ChiaetJUL 29, 2015Genetics & GenomicsPersonalized medicine could get a big boost from a new technique that is said to reduce the number of cells needed for e ...Written By: Ilene SchneiderMAY 04, 2015Genetics & GenomicsA team of Spanish researchers believes that a sixth DNA base called methyl-adenine could regulate the expression of cert ...Written By: Ilene SchneiderAPR 22, 2015Genetics & GenomicsCould the epigenome provide a new avenue for gene therapies and guiding stem cell differentiation?
Written By: Robert WoodardFEB 27, 2015Genetics & GenomicsAs an embryo is developing early on, cells and tissues for the person it will become are being formed for all time. Thes ...Written By: Judy O'RourkeFEB 25, 2015Genetics & GenomicsA treasure trove of findings on epigenomics, recently reported in the journal Nature, offers a useful guide for future s ...Written By: Judy O'RourkeFEB 09, 2015Cell & Molecular BiologyHealth professionals have long known the effects of stress on the human body. Stress can cause cardiac problems, high bl ...Written By: Brenda Kelley KimOCT 29, 2014Genetics & GenomicsThe BLUEPRINT consortium-a high-impact European research initiative-aims to help us better understand the mechanisms of ...Written By: Judy O'RourkeAUG 25, 2014Genetics & GenomicsMuch of the liver's metabolic function is governed by circadian rhythms - our own body clock - and UC Irvine researchers ...Written By: Ilene Schneider
OCT 24, 2017
Health & Medicine
When a woman is pregnant, it's often said that she is eating for two. While that may be true, what matters more than
...
Written By:
Brenda Kelley Kim
JAN 21, 2017
Cancer
Acting like cunning thieves in the night, pancreatic cancer can hack into their microenvironment to selfishly steal the
...
JAN 17, 2017
Genetics & Genomics
epigenetics initiates pancreatic cancer metastasis
Written By:
Jennifer Ellis
DEC 16, 2016
Cell & Molecular Biology
Reporting in Cell, scientists were able to extend the lifespan of mice that carry a genetic mutation that causes prematu
...
Written By:
Carmen Leitch
DEC 13, 2016
Cell & Molecular Biology
Brains are complex; studying brain function often involve simple organisms, like honeybees, which provided a finding tha
...
Written By:
Carmen Leitch
NOV 23, 2016
Microbiology
There is a rich community of microbes residing in the gastrointestinal tracts of animals including humans, the microbiom
...
Written By:
Carmen Leitch
NOV 20, 2016
Cell & Molecular Biology
A study published in Cell demonstrated how the brains of patients with different kinds of autism spectrum disorder (ASD)
...
Written By:
Carmen Leitch
AUG 22, 2016
Cell & Molecular Biology
Egg cells, or ovules in animals, remain dormant for many years after the start of reproductive age, and that is one reas
...
Written By:
Carmen Leitch
JUL 02, 2016
Videos
Our genes make us. They decide our height, the sound of our voice, and even how athletic we are. Yet, how is it that ide
...
Written By:
Julianne Chiaet
JAN 11, 2016
Genetics & Genomics
From the Sanger Institute/ EMBL-EBI Single Cell Genomics Centre, scientists say it is now possible to assay both DNA met
...
Written By:
Kara Marker
DEC 31, 2015
Health & Medicine
Our genes make us. They decide our height, the sound of our voice, and even how athletic we are. We’ll alwa
...
Written By:
Julianne Chiaet
JUL 29, 2015
Genetics & Genomics
Personalized medicine could get a big boost from a new technique that is said to reduce the number of cells needed for e
...
Written By:
Ilene Schneider
MAY 04, 2015
Genetics & Genomics
A team of Spanish researchers believes that a sixth DNA base called methyl-adenine could regulate the expression of cert
...
Written By:
Ilene Schneider
APR 22, 2015
Genetics & Genomics
Could the epigenome provide a new avenue for gene therapies and guiding stem cell differentiation?
Written By:
Robert Woodard
FEB 27, 2015
Genetics & Genomics
As an embryo is developing early on, cells and tissues for the person it will become are being formed for all time. Thes
...
Written By:
Judy O'Rourke
FEB 25, 2015
Genetics & Genomics
A treasure trove of findings on epigenomics, recently reported in the journal Nature, offers a useful guide for future s
...
Written By:
Judy O'Rourke
FEB 09, 2015
Cell & Molecular Biology
Health professionals have long known the effects of stress on the human body. Stress can cause cardiac problems, high bl
...
Written By:
Brenda Kelley Kim
OCT 29, 2014
Genetics & Genomics
The BLUEPRINT consortium-a high-impact European research initiative-aims to help us better understand the mechanisms of
...
Written By:
Judy O'Rourke
AUG 25, 2014
Genetics & Genomics
Much of the liver's metabolic function is governed by circadian rhythms - our own body clock - and UC Irvine researchers
...
Written By:
Ilene Schneider